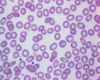
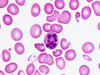
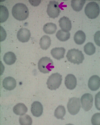

Immuno: Malabsorption CPC Flashcards
(33 cards)
List three causes of microcytic anaemia.
- Iron deficiency
- Thalassaemia trait
- Anaemia of a chronic disease
What is anisopoikilocytosis and which type of anaemia is it associated with?
- Variatios in size and shape of cells
- Associated with iron deficiency anaemia (and thalassaemia trait to a lesser degree)

What is basophilic stippling? List some causes.
- Basophilic appearance of red blood cells caused by the presence of aggregated ribosomal material
- Causes: beta-thalassaemia trait, lead poisoning, alcoholism, sidroblastic anaemia
Which condition do hypersegmented neutrophils tend to be present in?
Megaloblastic anaemia
List some causes of megaloblastic anaemia.
- B12 deficiency
- Folate deficiency
- Drugs
In which conditions might you see target cells (codocytes)?
- Iron deficiency
- Thalassaemia
- Hyposplenism
- Liver disease
NOTE: target cells have a high SA: V ratio

What are Howell-Jolly bodies? Which condition are they associated with?
- Nuclear remnants present within red blood cells
- Present in hyposplenism
List some causes of iron deficiency.
- Blood loss (major cause)
- Poor diet
- Malabsorption
- Combinations of the above
List some causes of B12 and folate deficiency.
- Poor diet
- Malabsorption
- Pernicious anaemia
List some causes of hyposplenism.
- Absent spleen: therapeutic, trauma
- Poorly-functioning spleen: inflammatory bowel disease, Coeliac disease, sickle cell disease, SLE
Which deficienceies are typically seen in Coeliac disease?
- Iron
- B12
- Folate
- Fat
- Calcium
Which deficiencies are typically seen in Crohn’s disease?
- B12
- Bile salts
Which deficiencies are typically seen in pancreatic disease?
- Fat
- Calcium
- B12
Which investigatio are typically performed in Coeliac disease?
- CRP and ESR
- Serological tests
- Upper GI endoscopy and distal duodenal biopsy (GOLD STANDARD)
Which gene locus does the heritability of coeliac disease tend to frequently map to?
MHC complex gene loci
Which HLA alleles are particularly common in patients with coeliac disease?
- HLA-DQ2 (80%) - DQA1*0501 and DQB1*02 alleles
- HLA-DQ8
Describe the T cell response to gluten in coeliac disease.
- Peptides from gluten (gliadin) are deamidated by tissue transglutaminase
- Deamidated gliadin is taken up by antigen-presenting cells and presented via HLA molecules to CD4+ T cells
- CD4+ T cell activation results in secretion of IFN-gamma and may increase IL-15 secretion
- These cytokines promote activation of intra-epithelial lymphocytes (gamma-delta T cells)
- The intraepithelial lymphocytes will kill epithelial cells via the NKG2D receptor (normally recognises the stress protein MICA)
Describe the B cell response to gluten in coeliac disease.
- B cells will process gluten antigens and present it via HLA molecules to CD4+ T cells
- The primed T cells will provide help to the B cells via CD40L: CD20 to allow B cells to undergo germinal centre reactions
- B cells undergo isotype switching and affinity maturation to become memory cells and plasma cells which produce antibodies against gliadin
Which type of anti-gliadin antibodies may be tested when investigating coeliac disease?
IgA antibodies
NOTE: it is not a very sensitive test and is outdated
B cells produce antibodies against tissue transglutaminase. Where is tTG expressed?
On endomysial cells
So, antibodies can be detected as anti-endomysial cell antibodies
What important test should be performed before checking anti-tTG and anti-endomysial antibody levels?
- IgA levels
- IgA deficiency can produce false-negative results
What are the characteristic histological features of coeliac disease?
- Subtotal villous atrophy with crypt hyperplasia
- Intra-epithelial lymphocytes

Describe the villous atrophy seen in coeliac disease.
- Normal villous: crypt ratio is about 2-4: 1
- In coeliac disease, villous height is reduced and crypts become hyperplastic
- This leads to a reduced or reversed villous: crypt ratio
- The mucosa remains the same thickness due to crypt hyperplasia
- However, decreased surface area (due to villous atrophy) leads to malabsorption
List some other causes of villous atrophy.
- Giardiasis
- Tropical sprue
- Crohn’s disease
- Radiation/chemotherapy
- Nutritional deficiencies
- Graft-versus-host disease
- Microvillous inclusion disease
- Common variable immunodeficiency



